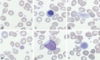
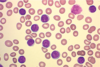

Haematological Malignancy in Practice Flashcards
(29 cards)
54 year old scaffolder
Tiredness progressively worse over last 2-3 weeks
What other symptoms should you ask about?
- SOB, dizziness, palpitations – anaemic symptoms
- Bleeding, diet - ?cause of anaemia
- Mood, appetite, sleep pattern, motivation - ?depression
- Weight gain, constipation, skin and hair changes - ?hypothyroidism
- Fevers, sweats, weight loss - ?infection, ?malignancy
- Systemic enquiry
Further questioning:
Over last 2 weeks - SOB and dizzy on climbing scaffold
Feeling hot and cold
Coughing up green phlegm
Examination:
Very pale
Temp 38.5
Dull percussion note R base with decreased air entry
Petichiae around ankles
what investigaitons would you do?
FBC, film
Coagulation screen
Haematinics – B12, folate, ferritin
U&Es, LFTs, CRP
Sputum culture
CXR
FBC Result:
Blood count shows he is very anaemic
Normal MCV and WCC
Very neutropenic
Normal reticulocyte count
Signs of significant bone marrow failure
what are some differential diagnosis?

A – Acute leukaemia
B – Aplastic anaemia
C - B12 deficiency
D – Metastatic ovarian cancer
Why or why not these conditions?
Could be B but most likely A as normal reticulocyte count
C not likely as MCV is normal
what is his diagnosis?
Blood film shows circulating blast cells

Acute myeloid leukaemia (AML)
Short history
Uncontrolled proliferation of immature myeloid cells therefore acute
This guy would be brought in and treated his acute sepsis with antibiotics and fluids etc, would be transfused as symptomatic anaemia and bleeding then would be diagnosed and treated his leukaemia with chemo and bone marrow as he is fit
Died post bone marrow transplant of graft vs host disease
20 year old student
Presents with 1 month history of gradually increasing neck swelling
Weight loss of half a stone
Generalised itch
Night sweats
O/E 2x3 cm cervical lymphadenopathy
Also axillary lymphadenopathy
FBC – normocytic normochromic anaemia, eosinophilia
what are some differential diagnosis?
Hodgkin’s Lymphoma
Non-Hodgkin’s lymphoma
Acute lymphoblastic leukaemia
Metastatic non haematological malignancy
Infections:
- viral – EBV, CMV, HIV
- Bacterial – draining, local lymph nodes
- TB, toxoplasma
whata re some fither invesitgations you could do?
Lymph node biopsy
Virology (particularly HIV)
what is the presentation of a lymphoma?
Lymphadenopathy
Splenomegaly +/- hepatomegaly
B symptoms:
- fever >38oC
- weight loss >10% body weight in 6 mths
- night sweats
Symptomatic anaemia or other cytopenias
Biopsy is critical in making the diagnosis
what is the diagnosis?

Staged by PET-CT scan
Stage IIB
Combination chemotherapy - ABVD

75 year old man:
Intermittent claudication for 2 years
Admitted with painful toe
Hb 159 120-160
MCV 74 82-99
RCC 6.2 3.8-5.0
WBC 11 4-10
Plts 850 140-400
Microcytic
Slightly leucocytosis and thrombocytosis
What are the causes of high platelets?
Infections
Post surgery / trauma
Malignancy
Iron deficiency
Inflammation – IBD, Rheumatoid arthritis
Primary myeloproliferative disorder
Vast majority of thrombocytosis is a reactive thing - About anything can cause secondary thrombocytosis
what investigations would you do for thrombocytosis
FBC
Blood film
Inflammatory markers (ESR, CRP)
Ferritin (is he iron deficienct?)
JAK2, CALR & MPL mutation screening - Often can make a diagnosis by looking at these mutations and looking at the case as a whole
Consider BCR-ABL
Other investigations if clinical suspicion of malignancy
Bone marrow examination not first line
Results:
ESR 24mm/hr, CRP <4
Ferritin 3 - iron deficient
Positive for JAK2 V617F mutation (one of the hall mark mutations for myeloproliferative disease)
What is the diagnosis?

Not 2 as CRP is normal
Seems like it is a vascular event and doesn’t seem to be any secondary infection
4 is also possible but presentation is not typical of this as normally you see splenomegaly and low counts
5 you would see microcytosis, raised red cell count but not in a 75 year old man as would of presented way before that and you wouldn’t see iron deficiency
So why is it not 3 – one of the hallmark features of PV is that they are iron deficient, they burn out their iron stores
3 is an isolated high platelet count where as in 1 the dominant thing is polycythaemia
You can see high platelets in PV but If you have polycythaemia then you have PV but if you just have high platelets then its just ET

75 year old man:
Iron deficient Polycythaemia Vera
Myeloproliferative disorder
what is his treatment?
Aspirin (antiplatelet), Venesection (remove blood), Hydroxycarbamide (inhibits production in bone marrow reducing platelet count)
55 year old man:
Low back pain – progressively worse
Tired last few months
Previously fit and well
No weight loss
Very common symptoms - And often not due to serious pathology
what are some key questions for back pain?
Duration
Getting worse?
Severity – interfering with sleep?
Radiation
Leg weakness or numbness?
Bladder or bowel disturbance?
what invesitgations may you do?
FBC, ESR
U&E, Ca, Phos, Immunoglobulins & protein electrophoresis
Bence Jones protein (or serum free light chains)
Xray of spine

what is seen on invesitgaiton?


what is the diagnosis?
Myeloma
Malignancy of plasma cells
what is the treatment of a myeloma?
Local – surgical decompression or radiotherapy
Systemic – induction chemotherapy (various regimens)
Bone protection (IV bisphosphonate (Bisphosphonate switch of osteoclasts and in myeloma they switch osteoclasts on and cause release of calcium into the bloodstream) Zolendronic acid)
Consolidation (autologous stem cell transplant
Maintenance (in clinical trial only in UK at present)
83 year old woman:
Admitted for bladder repair; denies other symptoms
On examination-marked splenomegaly
What might be the cause?
Low grade lymphoma
Chronic leukaemias (CML, CLL)
Myeloproliferative disorders
Portal hypertension / liver disease
Infiltration from sarcoidosis, other malignancies
Infections eg chronic malaria, visceral Leishmaniasis
(Don’t see in acute leukaemia as mainly in bone marrow and happens rapidly so spleen doesn’t have time to response)
83 year old woman
Blood count – Hb 100, MCV 96, WCC 1.2, Neuts 0.5, Plts 58
Neutropenic
Thrombocytopenic
Tear drops can be seen - associated with many conditions
In D you can see blast cell which shouldn’t be in peripheral blood, also red cell in C in peripheral blood which shouldn’t be there so should think is the bone marrow chucking them out because it is so full?
What is the diagnosis?
A.Chronic myeloid leukaemia
B.Myelofibrosis
C.Metastatic breast cancer in bone marrow
D.Chronic malaria
Giant platelets let us know it is B
- Leukoerythroblastic blood film with teardrop poikilocytes, blasts and giant platelets
- Extensive reticulin fibrosis in bone marrow

whata re the features of myelofibrosis?
De novo and transformed - Can arise on its own or transform form other myeloproliferative conditions like PV or ET
Splenomegaly (can be massive)
Symptoms from cytopenias or spleen
Weight loss, extreme tiredness
Leukoerythroblastic blood film (things form bone marrow spilling into peripheral blood), teardrop red cells
Marrow fibrosis – Reticulin stain (Key features if fibrosis in bone marrow
Most positive for one of JAK2/CALR/MPL mutations - Most of these people with have an identifiable mutation from myeloproliferative disease
what is the treatment of myelofibrosis?
Treatment very varies and same with prognosis
Transfusion, hydroxycarbamide, thalidomide, JAK2 inhibitors (Ruxolitinib), allogeneic stem cell transplantation
Ultimately allogenic stem cell transplantation is the curative treatment
Allografting is high risk so need to make sure risk of disease and symptoms outweigh the transplant
72 year old woman:
Blood count prior to elective cholecystectomy
Otherwise asymptomatic
Hb 120g/l (normal)
WCC 38.1
Lymph 34.7
Neut 3.1
Platelet 230
Raised WCC consisting of lymphocytes
Possible causes of lymphocytosis?
Viral infection (e.g. EBV, CMV, HIV) – too high for this
Other infections – TB, brucellosis, syphilis
Vasculitis
Acute lymphoblastic leukaemia
Chronic lymphocytic leukaemia
Lymphoma
Blood film:
Small, mature, homogenous lymphocytes
“smear” cells (cells broken down, don’t see in normal lypmhocytes)
Red cells, platelets normal
All look like the same
what are osme further tests?
(1) Flow cytometry
Cells labelled by monoclonal antibodies conjugated to fluorochromes directed against cell surface markers (tells you if B or T cells and if they carry abnormal markers)
(2) Look for underlying cause
EBV, CMV, HIV serology
Brucella, syphilis serology
Monospot test

Cells are small mature, no bone marrow failure, lymphoid in nature
CLL usually causes a peripheral blood leucocytosis





